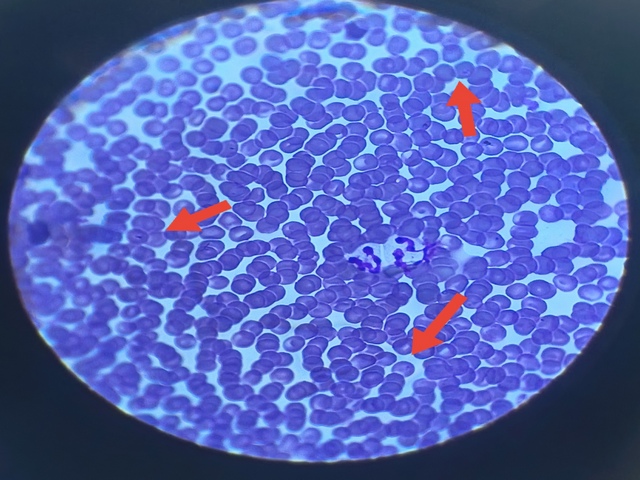

Пироплазмоз у собак: симптомы и лечение
В марте в ГБУ Брянской области «Унечская райветстанция» участились случаи обращения владельцев собак по поводу заболевания их питомцев пироплазмозом. Всего за месяц было диагностировано 11 случаев.
Пироплазмоз у собак — это сезонное заболевание, вызываемое простейшими кровепаразитами из рода Babesia. Основной путь заражения животных — укус инфицированного клеща. Клещ впрыскивает в организм слюну, в которой содержатся микроскопические паразиты. Сезонность заболевания выпадает на весну и осень. Однако в последнее время из-за малоснежных и теплых зим оно все чаще приобретает массовый характер, теперь случаи заболевания пироплазмозом регистрируют на протяжении всего года. Также значительно расширилась география распространения, это заболевание встречается на данный момент практически повсеместно. К тому же видоизменяется и симптоматика пироплазмоза. Многие явные клинические признаки заболевания могут отсутствовать (например, повышение температуры, бледность или желтушность слизистых, отказ от пищи и т.д.). В таких случаях определить наличие заболевания удается только после микроскопического исследования мазка крови и обнаружения возбудителя пироплазмоза.
Владельцам собак необходимо внимательно следить за состоянием и поведением своего питомца и при малейшем подозрении показать животное ветеринарному врачу. Отсутствие лечения в течение 2-4 дней приведет к нарушению работы дыхательной и сердечной систем, обезвоживанию, параличу и смерти животного. Самостоятельно организм собаки не сможет справиться с пироплазмозом, ни при каких условиях. Спасти питомца можно только с помощью введения противопаразитарного препарата и проведения вспомогательной терапии (снятия интоксикации, стабилизация общего состояния, регуляция эритропоэза, нормализация работы сердца и печени и др.).
Профилактика пироплазмоза состоит в обработке питомца противоклещевыми препаратами и тщательном осмотре его после каждой прогулки в период активности клещей. Среди препаратов можно отметить капли для наружного нанесения, аэрозоли, таблетки для внутреннего применения, ошейники, пропитанные противоклещевым составом.
Важно запомнить, что у собак не вырабатывается иммунитет после заболевания пироплазмозом. Поэтому, при малейшем изменении в самочувствии питомца, необходимо сразу обращаться к ветеринарному специалисту.